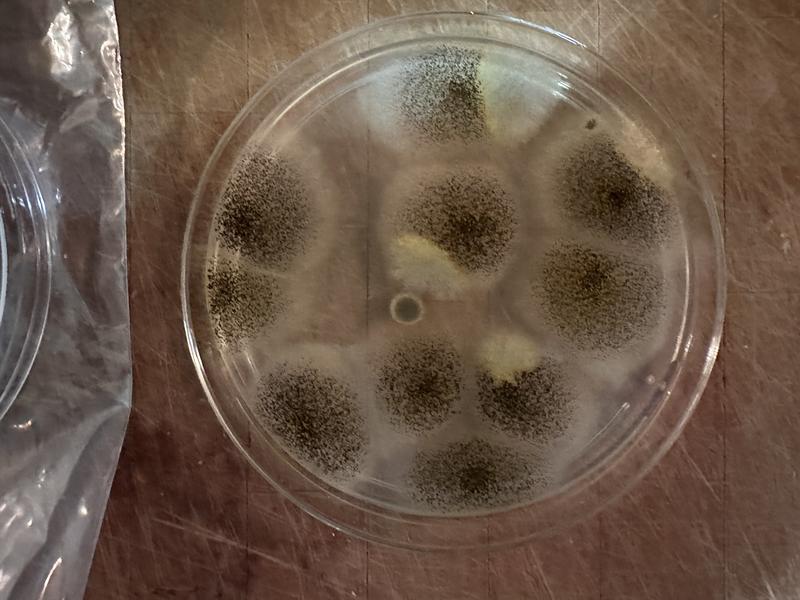
Review photo 1.

This paragraph should be hidden.


GermGuardian AC4825DLX 4-in-1 HEPA Filter & UVC Tower Air Purifier, Removes Allergens & Odours, Black, Small-Medium Room
- FREEAvailable
- Available
- Available
Pick up available 05:00 p.m., Dec 03
Only 6 left
Quebec residents: For information on maintenance and repair click here.
Product Details
The GermGuardian AC4825DLX 4-in-1 HEPA Filter UV-C Tower Air Purifier is designed to create a healthier home environment by effectively removing allergens, odours, and germs. Ideal for small to medium rooms, this air purifier features a True HEPA filter that captures up to 99.97% of airborne particles, including dust, pollen, and pet dander. The integrated UV-C light works with Titanium Dioxide to reduce airborne bacteria, viruses, and mould spores, providing added protection.
Ultra-Quiet Operation: the lowest setting can be used as gentle white noise at night for a quiet, restful sleep
Only one single filter needs to be replaced every 6-8 months depending on the use of the product
Zero Ozone Certified: meets UL 2998 and does not emit more than 0.005PPM as tested per UL 867
Cleans large rooms up to 740sq.ft. every 60 minutes or medium rooms up to 150sq.ft. every 12.5 minutes
Replacement filter is filter B (model FLT4825), to lengthen the life of your filter; a 4 pack of the carbon filters is also available (model FLT22CB4)
22" tall to fit in corners and tight spaces
Lightweight and easy to move between rooms
Ideal for allergy and asthma sufferers
Built-in filter change indicator for easy maintenance
3-year warranty
Colour: Black
| Part Number | AC4825DLX |
|---|---|
| Area Coverage (sq ft) | 153.00 ft² |
| Assembled Height (in) | 21.50 in |
| Assembled Length (in) | 10.25 in |
| Assembled Width (in) | 6.75 in |
| Assembled Weight (lb) | 8.55 lb |
| Wireless Standard Compatibility | No Wireless Connectivity |
| Smart System Compatibility | No Smart Technology |
| Filter Type | HEPA |
| Number of Speeds | 3 |
| Number of Cleaning Stages | 3 |
|---|---|
| Advanced Features | Light Bulb Indicator, Portable, Removes Bacteria, Removes Dust, Removes Mold, Removes Odour, Removes Pollen, Replaceable Filter, UVC Lamp |
| Product Use(s) | Indoor, UV Air Purification |
| Accessories List | No Accessories Included |
| Indicator Light Type | Power, Filter Life |
| Control Type | Mechanical |
| Cord Length (in) | 6.00 in |
| Colour | Black |
| Noise Level (dB) | 55 dB |
| Batteries Required Quantity | 0 |
| Replaceable/Rechargeable Battery | Not Applicable |
| Certifications | Energy Star |
| Clean Air Delivery Rate (CADR) | 100 |
| Enclosure Material | Plastic |
| Maximum Operating Temperature (°C) | 0.00 °C |
| Minimum Operating Temperature (°C) | 0.00 °C |
| Voltage (V) | 110 V |
| Wattage Rating (w) | 55 W |
- This product carries a 3 year exchange warranty redeemable at any Canadian Tire store.
- Pick Up is free at most stores (some stores require a minimum order value before tax)
- Shipping fee is based on size and weight of products and distance from address to store
- Same-Day Delivery costs $9.99 per order
- Online Ordering Information
- Most products can be returned or exchanged at any Canadian Tire store within 90 days of purchase
- Some products are non-refundable and non-exchangeable
- The return policy outlined above may not apply to the product you are currently viewing. For complete details and eligibility, please refer to our Return Policy for exceptions.
Shop Related Products
- Weekly Deals
- Customers Also Viewed
- Top Trending Products
- More From This Brand
Review Highlights
Pros
Cons
Reviews
Customer Images and Videos
Filter Reviews
- noise level
- smell
- satisfaction
- purchase
- quality
- cleaning
- value
- small
Senior citizen
Above mentioned one.
Good machine
Clean air
Fresh
Questions
Q: Does Can Tire sell the filter for this model? how much?
a year agoA: Yes: https://canadiantire.ca/en/pdp/germguardian-flt4825-genuine-combination-hepa-air-purifier-replacement-filter-b-for-ac4825-air-purifier-0438633p.html
a year agoHelpful?
Q: Does this come with an extra filter?
a year agoA: No it does not.
a year agoHelpful?
Q: its showing 2 filters in the photo...which 2 do i need to buy?
2 years agoA: You need the activated carbon pre-filter and the HEPA filter for the particular model of air purifier you buy.
2 years agoHelpful?
Q: How long does the filtres last ?
2 years agoA: It depends on how much there is in the air to filter out, but for reasonably clean air, they lasted about 6 months.
2 years agoHelpful?
Q: Does this really work for cigarette smell?
3 years agoA: Not sure with cigarette smell as we are non smokers. But it does filter the air well in a mid size room. You can smell the cleaner air if that makes sense.
3 years agoHelpful?
Q: From where to buy the filter and how much it may cost?
3 years agoA: There is a red light indicator that is on all the time I just got a new one is it a defect or its just a light
a year agoHelpful?
Q: does the filter need to be replaced or can it be cleaned and reused?
4 years agoA: The filter needs to be replaced.
4 years agoHelpful?
Q: Is it able to filter out dust mites?
a year agoA: Yes
a year agoHelpful?
Q: Red light came on indicating change filter. Filter has been changed with germ guardian hepa B filter and the red light still flashes. What do I do now?
2 years agoA: Hi, Please Hold down UV button for 5 seconds to reset both indicators. Hope this helps. Have a great day!
2 years agoHelpful?
Q: What replacement filters to I buy
3 years agoA: The replacement filter for this purifier is: 43-8633 GermGuardian Air Purifier GENUINE Replacement Filter for AC4825
3 years agoHelpful?